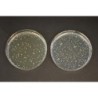
Основа TOS-пропионатного агара
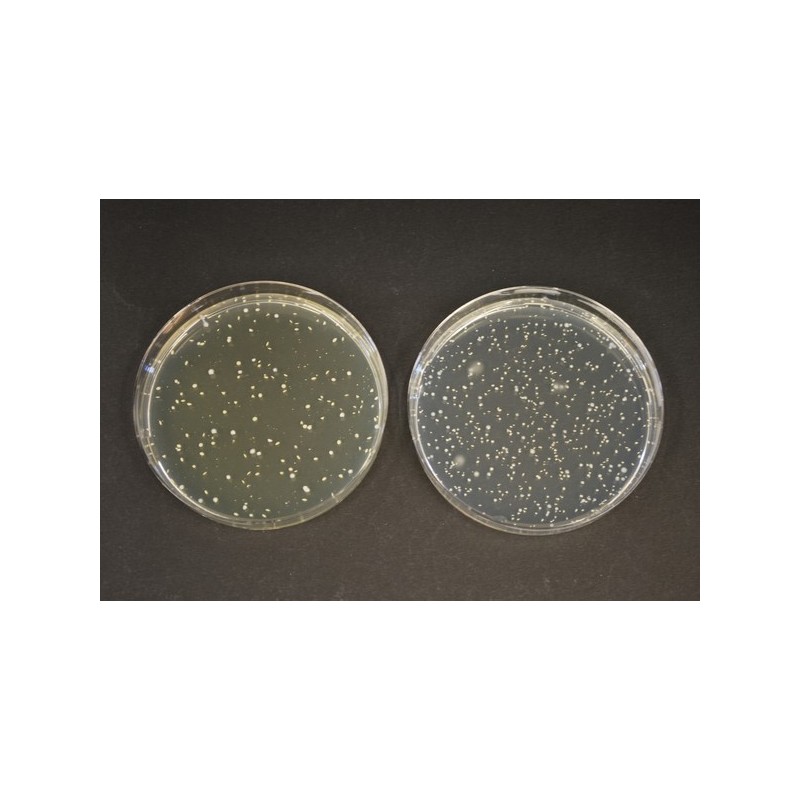
Основа TOS-пропионатного агара

TOS-ПРОПИОНАТНЫЙ АГАР (ОСНОВА)
Среда для подсчета бифидобактерий в молочных продуктах
Состав среды (г/л)
Пептон из казеина - 10,0;
дрожжевой экстракт - 1,0;
KH2PO4 - 3,0;
K2HPO4 - 4,8;
(NH4)2SO4 - 3,0;
MgSO4*7H2O – 0,2;
L-цистеин - 0,5;
пропионат натрия – 15;
галактоолигосахарид TOS – 10;
агар-агар – 15,0.
Селективная среда TOS пропионатный агар в сочетании с селективной добавкой мупироцина лития (MUP) позволяет определять количество бифидобактерий в стартовых культурах и различных молочных продуктах таких, как ферментированное и неферментированное молоко, сухое молоко и детское питание. Рост других молочнокислых бактерий в значительной степени ингибируется, таким образом, нет необходимости подтверждать выросшие колонии бифидобактерий. Определение бифидобактерий выполняется методом посева и подсчета на чашках Петри, которые инкубируются в анаэробных условиях при температуре 37оС.
Хранить при температуре от + 15 °C до + 25 °C.
Не удаётся отправить вашу оценку отзыва
Пожаловаться на комментарий
Жалоба отправлена
Не удаётся отправить вашу жалобу
Оставьте свой отзыв
Отзыв отправлен
Не удаётся отправить отзыв
TOS-ПРОПИОНАТНЫЙ АГАР (ОСНОВА)
check_circle
check_circle











